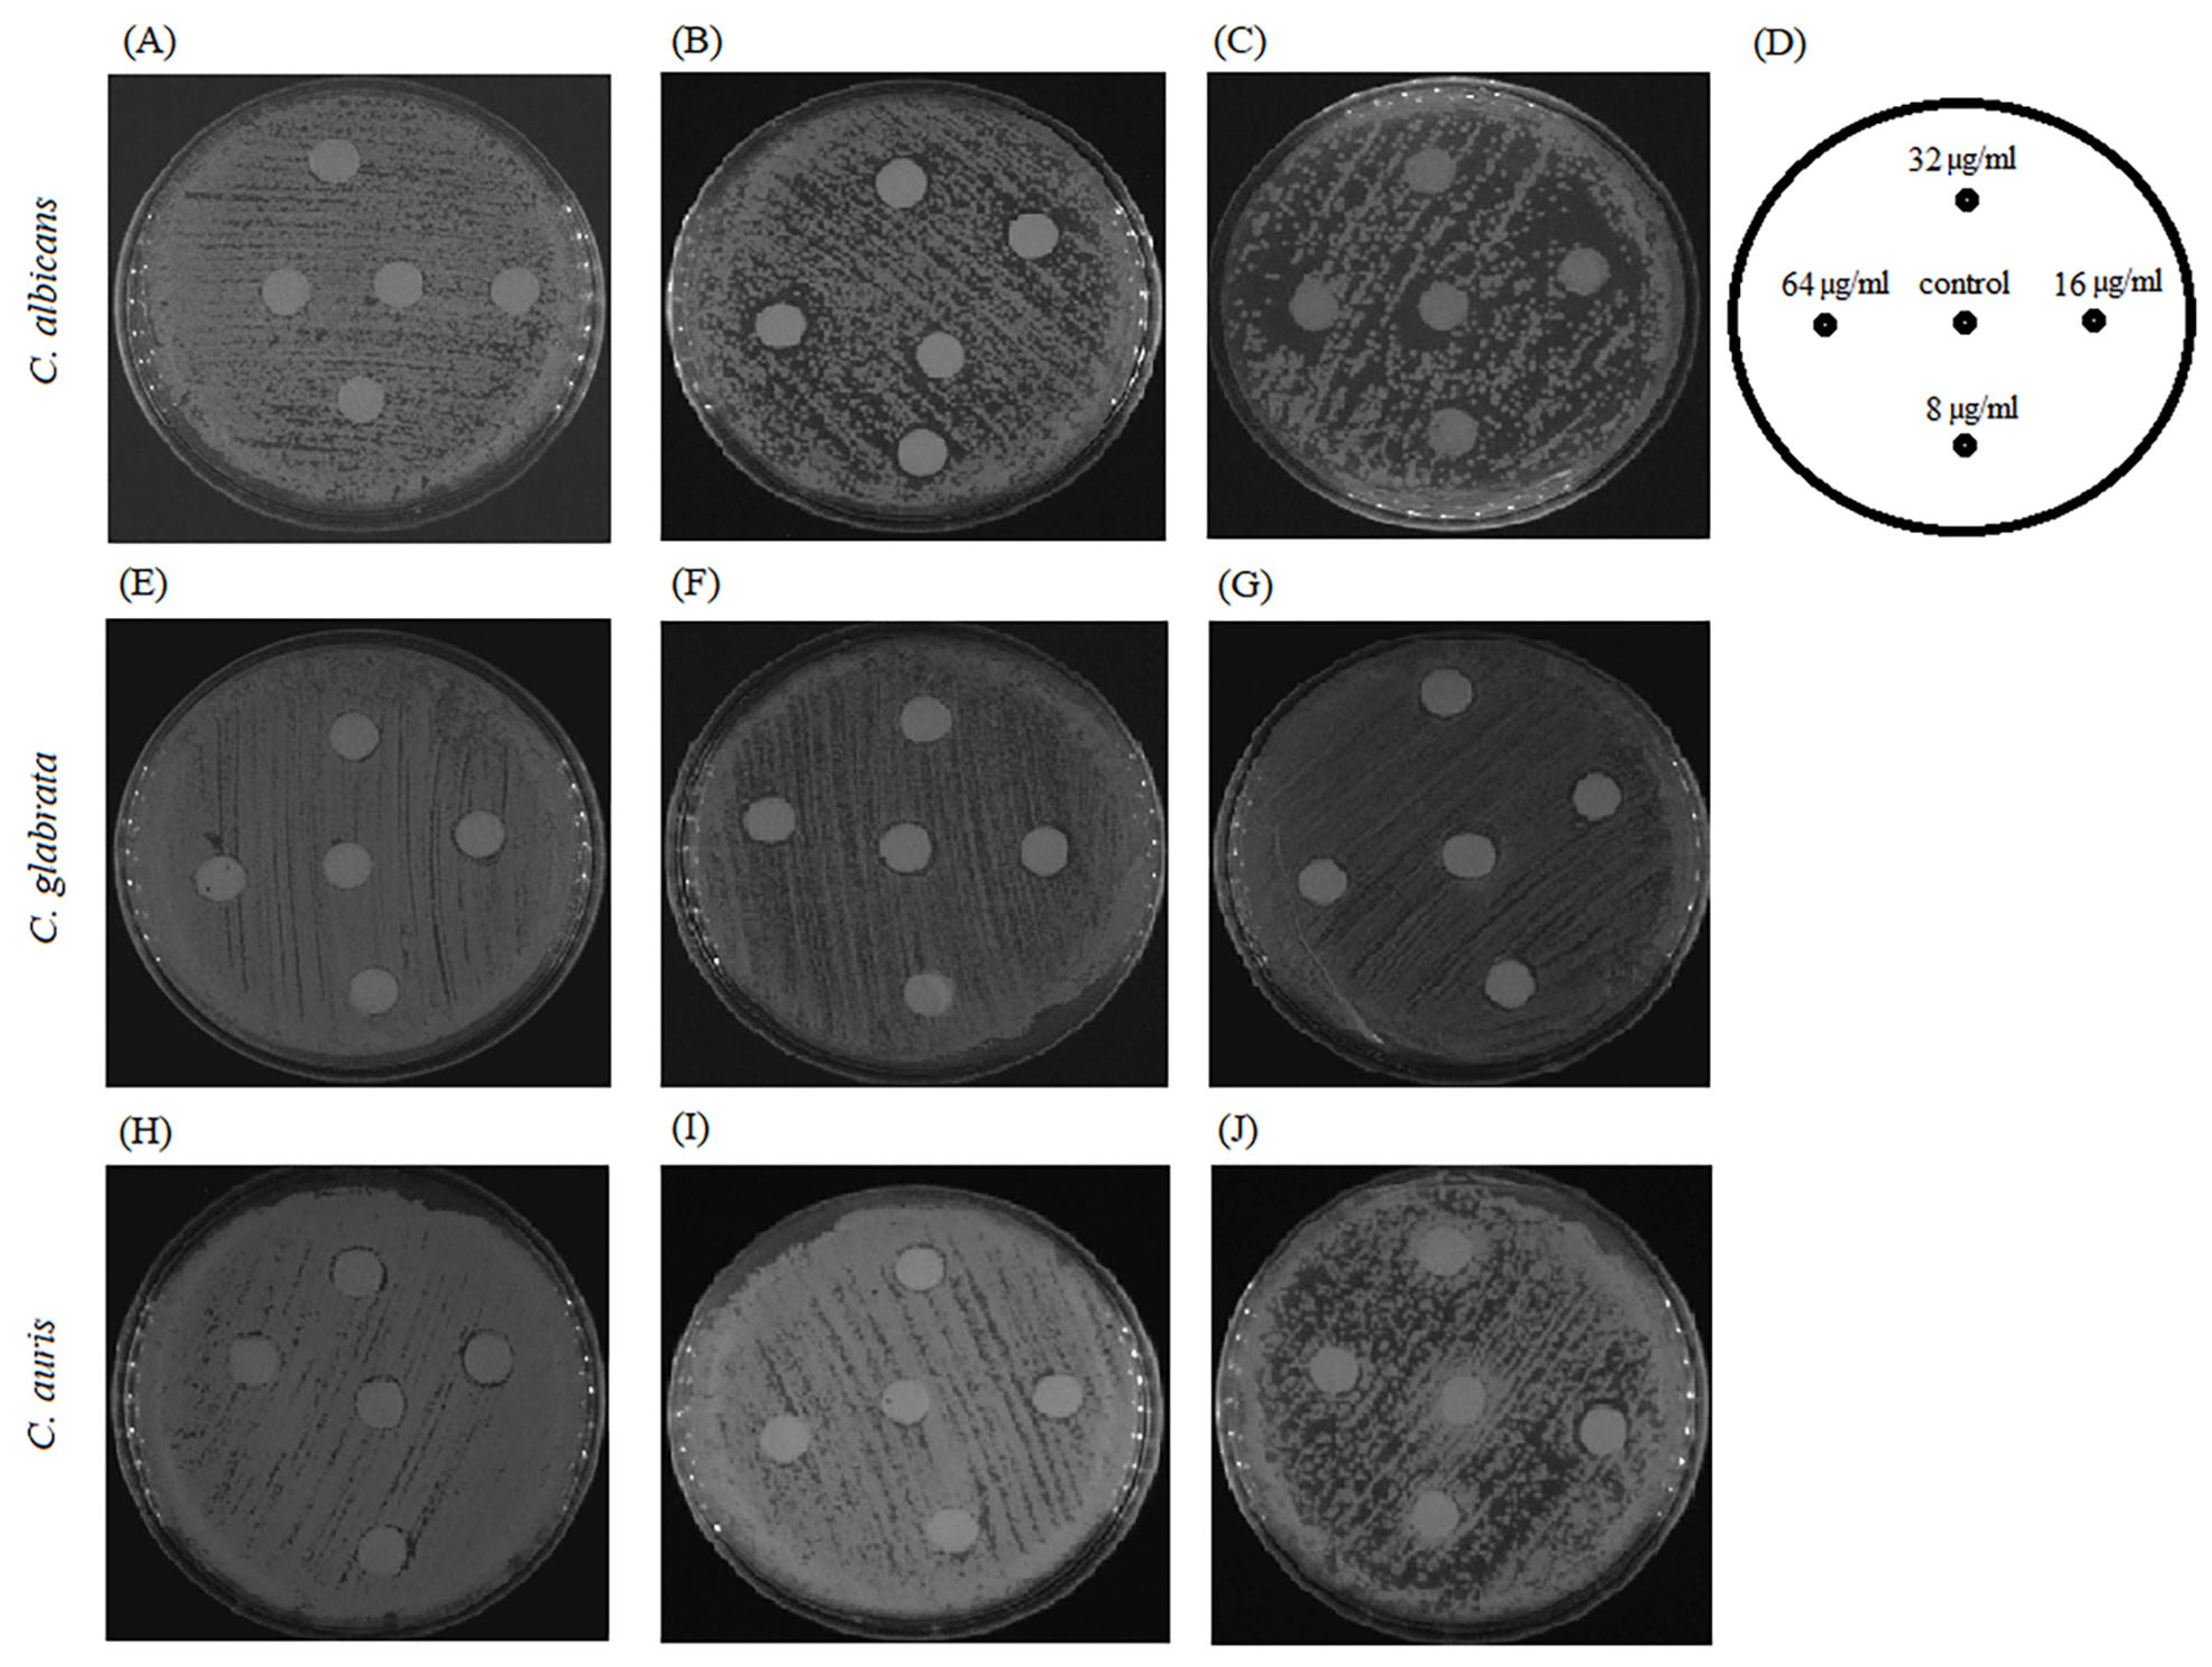
Pharmaceuticals 17 00089 g012

Biochanin A Inhibits the Growth and Biofilm of Candida Species
Abstract
1. Introduction
2. Results
2.1. Antifungal Susceptibility of Planktonic Cells
2.2. Effect of BCA on Adhesion of Cells
2.3. Activity of BCA against Biofilm Formation and Mature Biofilm
2.4. Inhibitory Activity of BCA against the Transition of Candida from Yeast to Hyphae
2.5. Effect of BCA on C. albicans Gene Expression
2.6. Effect of Biochanin A on the Cell Wall and Cell Membrane of C. Albicans
2.7. Combination of BCA and Fluconazole against Fluconazole-Resistant Candida Species
3. Discussion
3.1. BCA Inhibits the Growth of Candida Species
3.2. BCA Inhibits the Biofilm of Candida Species
3.3. BCA Causes Physical Destruction of Cell Membranes and Cell Walls
3.4. BCA Does Not Interact with Fluconazole
4. Materials and Methods
4.1. Strains
4.2. Chemicals and Microbiological Media
4.3. Antifungal Susceptibility Assay
4.4. Adhesion Assay
4.5. Crystal Violet Assay
4.6. MTT Assay
4.7. Cell Surface Hydrophobicity (CSH)
4.8. Morphological Transition
4.9. Inhibition of Biofilm Formation
4.10. Mature Biofilm Eradication
4.11. Relative Quantification by Real-Time Reverse Transcriptase qRT-PCR
4.12. Aniline Blue and Calcofluor White Staining
4.13. PI Staining
4.14. DPH Assay
4.15. Agar Disk Diffusion Test
4.16. Statistical Analysis
5. Conclusions
Author Contributions
Funding
Institutional Review Board Statement
Informed Consent Statement
Data Availability Statement
Conflicts of Interest
References
- Yu, C.; Zhang, P.; Lou, L.; Wang, Y. Perspectives Regarding the Role of Biochanin A in Humans. Front. Pharmacol. 2019, 10, 793. [Google Scholar] [CrossRef] [PubMed]
- Setchell, K.D.; Brown, N.M.; Desai, P.; Zimmer-Nechemias, L.; Wolfe, B.E.; Brashear, W.T.; Kirschner, A.S.; Cassidy, A.; Heubi, J.E. Bioavailability of pure isoflavones in healthy humans and analysis of commercial soy isoflavone supplements. J. Nutr. 2001, 131 (Suppl. S4), 1362S–1375S. [Google Scholar] [CrossRef] [PubMed]
- Roberts, D.W.; Doerge, D.R.; Churchwell, M.I.; Da Costa, G.G.; Marques, M.M.; Tolleson, W.H. Inhibition of extrahepatic human cytochromes P450 1A1 and 1B1 by metabolism of isoflavones found in Trifolium pratense (red clover). J. Agric. Food Chem. 2004, 52, 6623–6632. [Google Scholar] [CrossRef]
- Křížová, L.; Dadáková, K.; Kašparovská, J.; Kašparovský, T. Isoflavones. Molecules 2019, 24, 1076. [Google Scholar] [CrossRef] [PubMed]
- Luo, Q.; Shi, X.; Ding, J.; Ma, Z.; Chen, X.; Leng, Y.; Zhang, X.; Liu, Y. Network Pharmacology Integrated Molecular Docking Reveals the Antiosteosarcoma Mechanism of Biochanin A. Evid. Based Complement. Altern. Med. 2019, 6, 1410495. [Google Scholar] [CrossRef] [PubMed]
- Liang, F.; Cao, W.; Huang, Y.; Fang, Y.; Cheng, Y.; Pan, S.; Xu, X. Isoflavone biochanin A, a novel nuclear factor erythroid 2-related factor 2 (Nrf2)-antioxidant response element activator, protects against oxidative damage in HepG2 cells. Biofactors 2019, 45, 563–574. [Google Scholar] [CrossRef]
- Puli, S.; Lai, J.C.; Bhushan, A. Inhibition of matrix degrading enzymes and invasion in human glioblastoma (U87MG) cells by isoflavones. J. Neurooncol. 2006, 79, 135–142. [Google Scholar] [CrossRef]
- Medjakovic, S.; Jungbauer, A. Red clover isoflavones biochanin A and formononetin are potent ligands of the human aryl hydrocarbon receptor. J. Steroid Biochem. Mol. Biol. 2008, 108, 171–177. [Google Scholar] [CrossRef]
- van Duursen, M.B.M. Modulation of estrogen synthesis and metabolism by phytoestrogens in vitro and the implications for women’s health. Toxicol. Res. 2017, 6, 772–794. [Google Scholar] [CrossRef]
- Sithisarn, P.; Michaelis, M.; Schubert-Zsilavecz, M.; Cinatl, J., Jr. Differential antiviral and anti-inflammatory mechanisms of the flavonoids biochanin A and baicalein in H5N1 influenza A virus-infected cells. Antivir. Res. 2013, 97, 41–48. [Google Scholar] [CrossRef]
- Sklenickova, O.; Flesar, J.; Kokoska, L.; Vlkova, E.; Halamova, K.; Malik, J. Selective growth inhibitory effect of biochanin A against intestinal tract colonizing bacteria. Molecules 2010, 15, 1270–1279. [Google Scholar] [CrossRef] [PubMed]
- Hanski, L.; Genina, N.; Uvell, H.; Malinovskaja, K.; Gylfe, Å.; Laaksonen, T.; Kolakovic, R.; Mäkilä, E.; Salonen, J.; Hirvonen, J.; et al. Inhibitory activity of the isoflavone biochanin A on intracellular bacteria of genus Chlamydia and initial development of a buccal formulation. PLoS ONE 2014, 9, e115115. [Google Scholar] [CrossRef] [PubMed]
- Zhao, X.; Tang, X.; Guo, N.; An, Y.; Chen, X.; Shi, C.; Wang, C.; Li, Y.; Li, S.; Xu, H.; et al. Biochanin a Enhances the defense against salmonella enterica infection through AMPK/ULK1/mTOR-mediated autophagy and extracellular traps and reversing SPI1-dependent macrophage (MΦ) M2 polarization. Front. Cell. Infect. Microbiol. 2018, 8, 318. [Google Scholar] [CrossRef] [PubMed]
- Bai, X.; Shen, Y.; Zhang, T.; Meng, R.; Zhang, Y.; Deng, Y.; Guo, N. Anti-biofilm activity of biochanin A against Staphylococcus aureus. Appl. Microbiol. Biotechnol. 2023, 107, 867–879. [Google Scholar] [CrossRef]
- Zou, D.; Xie, K.; Wang, H.; Chen, Y.; Xie, M. Inhibitory effects of biochanin A on the efflux pump of methicillin-resistant Staphylococcus aureus (MRSA). Wei Sheng Wu Xue Bao = Acta Microbiol. Sin. 2014, 54, 1204–1211. [Google Scholar]
- Jin, H.; Qi, C.; Zou, Y.; Kong, Y.; Ruan, Z.; Ding, H.; Xie, X.; Zhang, J. Biochanin A partially restores the activity of ofloxacin and ciprofloxacin against topoisomerase IV mutation-associated fluoroquinolone-resistant Ureaplasma species. J. Med. Microbiol. 2017, 66, 1545–1553. [Google Scholar] [CrossRef]
- Lechner, D.; Gibbons, S.; Bucar, F. Plant phenolic compounds as ethidium bromide efflux inhibitors in Mycobacterium smegmatis. J. Antimicrob. Chemother. 2008, 62, 345–348. [Google Scholar] [CrossRef]
- Sartorelli, P.; Carvalho, C.S.; Reimão, J.Q.; Ferreira, M.J.; Tempone, A.G. Antiparasitic activity of biochanin A, an isolated isoflavone from fruits of Cassia fistula (Leguminosae). Parasitol. Res. 2009, 104, 311–314. [Google Scholar] [CrossRef]
- Yang, S.; Zhou, J.; Li, D.; Shang, C.; Peng, L.; Pan, S. The structure-antifungal activity relationship of 5,7-dihydroxyflavonoids against Penicillium italicum. Food Chem. 2017, 224, 26–31. [Google Scholar] [CrossRef]
- Weidenbörner, M.; Holger Hindorf, H.; Chandra Jha, H.; Tsotsonos, P.; Egge, H. Antifungal activity of isoflavonoids in different reduced stages on Rhizoctonia solani and Sclerotium rolfsii. Phytochemistry 1990, 29, 801–803. [Google Scholar] [CrossRef]
- Lopes, N.P.; Kato, M.J.; Yoshida, M. Antifungal constituents from roots of Virola surinamensis. Phytochemistry 1999, 51, 29–33. [Google Scholar] [CrossRef]
- Nikolic, I.L.; Savic, I.M.; Popsavin, M.M.; Rakic, S.J.; Mihajilov-Krstev, T.M.; Ristic, I.S.; Eric, S.P.; Savić-Gajic, I.M. Preparation, characterization and antimicrobial activity of inclusion complex of biochanin A with (2-hydroxypropyl)-β-cyclodextrin. J. Pharm. Pharmacol. 2018, 70, 1485–1493. [Google Scholar] [CrossRef] [PubMed]
- Lamoth, F.; Lockhart, S.R.; Berkow, E.L.; Calandra, T. Changes in the epidemiological landscape of invasive candidiasis. J. Antimicrob. Chemother. 2018, 73 (Suppl. S1), i4–i13. [Google Scholar] [CrossRef] [PubMed]
- Pappas, P.G.; Lionakis, M.S.; Arendrup, M.C.; Ostrosky-Zeichner, L.; Kullberg, B.J. Invasive candidiasis. Nat. Rev. Dis. Primers 2018, 4, 18026. [Google Scholar] [CrossRef]
- World Health Organization. WHO Fungal Priority Pathogens List to Guide Research, Development and Public Health Action. 2022. Available online: https://www.who.int/publications/i/item/9789240060241 (accessed on 25 October 2022).
- Chow, B.D.; Reardon, J.R.; Perry, E.O.; Laforce-Nesbitt, S.S.; Tucker, R.; Bliss, J.M. Expressed Breast Milk as a Predictor of Neonatal Yeast Colonization in an Intensive Care Setting. J. Pediatr. Infect. Dis. Soc. 2014, 3, 213–220. [Google Scholar] [CrossRef] [PubMed]
- Lopes, J.P.; Lionakis, M.S. Pathogenesis and virulence of Candida albicans. Virulence 2022, 13, 89–121. [Google Scholar] [CrossRef] [PubMed]
- Schmiedel, Y.; Zimmerli, S. Common invasive fungal diseases: An overview of invasive candidiasis, aspergillosis, cryptococcosis, and Pneumocystis pneumonia. Swiss Med. Wkly. 2016, 146, w14281. [Google Scholar] [CrossRef] [PubMed]
- Perfect, J.R. The antifungal pipeline: A reality check. Nat. Rev. Drug Discov. 2017, 16, 603–616. [Google Scholar] [CrossRef]
- Rauseo, A.M.; Coler-Reilly, A.; Larson, L.; Spec, A. Hope on the Horizon: Novel Fungal Treatments in Development. Open Forum Infect. Dis. 2020, 7, ofaa016. [Google Scholar] [CrossRef]
- Wall, G.; Montelongo-Jauregui, D.; Vidal Bonifacio, B.; Lopez-Ribot, J.L.; Uppuluri, P. Candida albicans biofilm growth and dispersal: Contributions to pathogenesis. Curr. Opin. Microbiol. 2019, 52, 1–6. [Google Scholar] [CrossRef]
- Ramage, G.; Martínez, J.P.; López-Ribot, J.L. Candida biofilms on implanted biomaterials: A clinically significant problem. FEMS Yeast Res. 2006, 6, 979–986. [Google Scholar] [CrossRef] [PubMed]
- Nobile, C.J.; Johnson, A.D. Candida albicans Biofilms and Human Disease. Annu. Rev. Microbiol. 2015, 69, 71–92. [Google Scholar] [CrossRef] [PubMed]
- Pereira, R.; Dos Santos Fontenelle, R.O.; de Brito, E.H.S.; de Morais, S.M. Biofilm of Candida albicans: Formation, regulation and resistance. J. Appl. Microbiol. 2021, 131, 11–22. [Google Scholar] [CrossRef] [PubMed]
- Mota Fernandes, C.; Dasilva, D.; Haranahalli, K.; McCarthy, J.B.; Mallamo, J.; Ojima, I.; Del Poeta, M. The Future of Antifungal Drug Therapy: Novel Compounds and Targets. Antimicrob. Agents Chemother. 2021, 65, e01719-20. [Google Scholar] [CrossRef] [PubMed]
- Taff, H.T.; Mitchell, K.F.; Edward, J.A.; Andes, D.R. Mechanisms of Candida biofilm drug resistance. Future Microbiol. 2013, 8, 1325–1337. [Google Scholar] [CrossRef] [PubMed]
- Arendrup, M.C.; Patterson, T.F. Multidrug-Resistant Candida: Epidemiology, Molecular Mechanisms, and Treatment. J. Infect. Dis. 2017, 216 (Suppl. S3), S445–S451. [Google Scholar] [CrossRef] [PubMed]
- Bhattacharya, S.; Sae-Tia, S.; Fries, B.C. Candidiasis and Mechanisms of Antifungal Resistance. Antibiotics 2020, 9, 312. [Google Scholar] [CrossRef]
- Seleem, D.; Pardi, V.; Murata, R.M. Review of flavonoids: A diverse group of natural compounds with anti-Candida albicans activity in vitro. Arch. Oral Biol. 2017, 76, 76–83. [Google Scholar] [CrossRef]
- Tungmunnithum, D.; Thongboonyou, A.; Pholboon, A.; Yangsabai, A. Flavonoids and Other Phenolic Compounds from Medicinal Plants for Pharmaceutical and Medical Aspects: An Overview. Medicines 2018, 5, 93. [Google Scholar] [CrossRef]
- Luca, S.V.; Macovei, I.; Bujor, A.; Miron, A.; Skalicka-Woźniak, K.; Aprotosoaie, A.C.; Trifan, A. Bioactivity of dietary polyphenols: The role of metabolites. Crit. Rev. Food Sci. Nutr. 2020, 60, 626–659. [Google Scholar] [CrossRef]
- Yazdanyar, A.; Essmann, M.; Larsen, B. Genistein effects on growth and cell cycle of Candida albicans. J. Biomed. Sci. 2001, 8, 153–159. [Google Scholar] [CrossRef] [PubMed]
- Seleem, D.; Benso, B.; Noguti, J.; Pardi, V.; Murata, R.M. In Vitro and In Vivo Antifungal Activity of Lichochalcone-A against Candida albicans Biofilms. PLoS ONE 2016, 11, e0157188. [Google Scholar] [CrossRef] [PubMed]
- Han, Y. Rutin has therapeutic effect on septic arthritis caused by Candida albicans. Int. Immunopharmacol. 2009, 9, 207–211. [Google Scholar] [CrossRef] [PubMed]
- Rocha, M.F.G.; Sales, J.A.; da Rocha, M.G.; Galdino, L.M.; de Aguiar, L.; Pereira-Neto, W.A.; de Aguiar Cordeiro, R.; Castelo-Branco, D.S.C.M.; Sidrim, J.J.C.; Brilhante, R.S.N. Antifungal effects of the flavonoids kaempferol and quercetin: A possible alternative for the control of fungal biofilms. Biofouling 2019, 35, 320–328. [Google Scholar] [CrossRef] [PubMed]
- Janeczko, M.; Gmur, D.; Kochanowicz, E.; Górka, K.; Skrzypek, T. Inhibitory effect of a combination of baicalein and quercetin flavonoids against Candida albicans strains isolated from the female reproductive system. Fungal Biol. 2022, 126, 407–420. [Google Scholar] [CrossRef] [PubMed]
- Tan, Y.; Lin, Q.; Yao, J.; Zhang, G.; Peng, X.; Tian, J. In vitro outcomes of quercetin on Candida albicans planktonic and biofilm cells and in vivo effects on vulvovaginal candidiasis. Evidences of its mechanisms of action. Phytomedicine 2023, 114, 154800. [Google Scholar] [CrossRef] [PubMed]
- Chow, E.W.L.; Pang, L.M.; Wang, Y. From Jekyll to Hyde: The Yeast-Hyphal Transition of Candida albicans. Pathogens 2021, 10, 859. [Google Scholar] [CrossRef]
- Silva, S.; Negri, M.; Henriques, M.; Oliveira, R.; Williams, D.W.; Azeredo, J. Candida glabrata, Candida parapsilosis and Candida tropicalis: Biology, epidemiology, pathogenicity and antifungal resistance. FEMS Microbiol. Rev. 2012, 36, 288–305. [Google Scholar] [CrossRef]
- Malinovská, Z.; Čonková, E.; Váczi, P. Biofilm Formation in Medically Important Candida Species. J. Fungi 2023, 9, 955. [Google Scholar] [CrossRef]
- Yang, L.; Sui, Y.; Zhong, L.; Ma, T.; Ma, Z.; Liu, X. Carnosol inhibits the growth and biofilm of Candida albicans. J. Med. Mycol. 2022, 32, 101234. [Google Scholar] [CrossRef]
- Lee, H.S.; Kim, Y. Antifungal Activity of Salvia miltiorrhiza Against Candida albicans Is Associated with the Alteration of Membrane Permeability and (1,3)-β-D-Glucan Synthase Activity. J. Microbiol. Biotechnol. 2016, 26, 610–617. [Google Scholar] [CrossRef] [PubMed]
- Di Santo, R. Natural products as antifungal agents against clinically relevant pathogens. Nat. Prod. Rep. 2010, 27, 1084–1098. [Google Scholar] [CrossRef] [PubMed]
- Negri, M.; Salci, T.P.; Shinobu-Mesquita, C.S.; Capoci, I.R.; Svidzinski, T.I.; Kioshima, E.S. Early state research on antifungal natural products. Molecules 2014, 19, 2925–2956. [Google Scholar] [CrossRef] [PubMed]
- Dorsaz, S.; Snäkä, T.; Favre-Godal, Q.; Maudens, P.; Boulens, N.; Furrer, P.; Ebrahimi, S.N.; Hamburger, M.; Allémann, E.; Gindro, K.; et al. Identification and Mode of Action of a Plant Natural Product Targeting Human Fungal Pathogens. Antimicrob. Agents Chemother. 2017, 61, e00829-17. [Google Scholar] [CrossRef] [PubMed]
- Manzano-Gayosso, P.; Méndez-Tovar, L.J.; Hernández-Hernández, F.; López-Martínez, R. La resistencia a los antifúngicos: Un problema emergente en México (Antifungal resistance: An emerging problem in Mexico). Gac. Med. Mex. 2008, 144, 23–26. [Google Scholar] [PubMed]
- Ruan, S.Y.; Hsueh, P.R. Invasive candidiasis: An overview from Taiwan. J. Formos. Med. Assoc. 2009, 108, 443–451. [Google Scholar] [CrossRef]
- Makanjuola, O.; Bongomin, F.; Fayemiwo, S.A. An Update on the Roles of Non-albicans Candida Species in Vulvovaginitis. J. Fungi 2018, 4, 121. [Google Scholar] [CrossRef]
- Mbaveng, A.T.; Kuete, V.; Ngameni, B.; Beng, V.P.; Ngadjui, B.T.; Meyer, J.J.; Lall, N. Antimicrobial activities of the methanol extract and compounds from the twigs of Dorstenia mannii (Moraceae). BMC Complement. Altern. Med. 2012, 12, 83. [Google Scholar] [CrossRef]
- Belofsky, G.; Kolaczkowski, M.; Adams, E.; Schreiber, J.; Eisenberg, V.; Coleman, C.M.; Zou, Y.; Ferreira, D. Fungal ABC transporter-associated activity of isoflavonoids from the root extract of Dalea formosa. J. Nat. Prod. 2013, 76, 915–925. [Google Scholar] [CrossRef]
- Ziberna, L.; Fornasaro, S.; Cvorovic, J.; Tramer, F.; Passamonti, S. Chapter 37—Bioavailability of flavonoids: The role of cell membrane transporters. In Polyphenols in Human Health and Disease; Watson, R.R., Preedy, V.R., Zibadi, S., Eds.; Academic Press: Cambridge, MA, USA, 2014; pp. 489–511. [Google Scholar]
- Nett, J.E.; Andes, R.D. Fungal Biofilms: In Vivo Models for Discovery of Anti-Biofilm Drugs. Microbiol. Spectr. 2015, 3, E30. [Google Scholar] [CrossRef]
- Desai, J.V. Candida albicans Hyphae: From Growth Initiation to Invasion. J. Fungi 2018, 4, 10. [Google Scholar] [CrossRef] [PubMed]
- Chen, H.; Zhou, X.; Ren, B.; Cheng, L. The regulation of hyphae growth in Candida albicans. Virulence 2020, 11, 337–348. [Google Scholar] [CrossRef] [PubMed]
- Silva, B.L.R.; Simão, G.; Campos, C.D.L.; Monteiro, C.R.A.V.; Bueno, L.R.; Ortis, G.B.; Mendes, S.J.F.; Moreira, I.V.; Maria-Ferreira, D.; Sousa, E.M.; et al. In Silico and In Vitro Analysis of Sulforaphane Anti-Candida Activity. Antibiotics 2022, 11, 1842. [Google Scholar] [CrossRef] [PubMed]
- Lohse, M.B.; Gulati, M.; Johnson, A.D.; Nobile, C.J. Development and regulation of single- and multi-species Candida albicans biofilms. Nat. Rev. Microbiol. 2018, 16, 19–31. [Google Scholar] [CrossRef]
- Singla, R.K.; Dubey, A.K. Molecules and Metabolites from Natural Products as Inhibitors of Biofilm in Candida spp. pathogens. Curr. Top. Med. Chem. 2019, 19, 2567–2578. [Google Scholar] [CrossRef] [PubMed]
- Mishra, R.; Panda, A.K.; De Mandal, S.; Shakeel, M.; Bisht, S.S.; Khan, J. Natural Anti-biofilm Agents: Strategies to Control Biofilm-Forming Pathogens. Front. Microbiol. 2020, 11, 566325. [Google Scholar] [CrossRef] [PubMed]
- Gow, N.A.R.; Hube, B. Importance of the Candida albicans cell wall during commensalism and infection. Curr. Opin. Microbiol. 2012, 15, 406–412. [Google Scholar] [CrossRef]
- Fiołka, M.J.; Mieszawska, S.; Czaplewska, P.; Szymańska, A.; Stępnik, K.; Sofińska-Chmiel, W.; Buchwald, T.; Lewtak, K. Candida albicans cell wall as a target of action for the protein-carbohydrate fraction from coelomic fluid of Dendrobaena veneta. Sci. Rep. 2020, 10, 16352. [Google Scholar] [CrossRef]
- Ghannoum, M.A.; Janini, G.; Khamis, L.; Radwan, S.S. Dimorphism-associated variations in the lipid composition of Candida albicans. Microbiology 1986, 132, 2367–2375. [Google Scholar] [CrossRef]
- Repáková, J.; Holopainen, J.M.; Morrow, M.R.; McDonald, M.C.; Capková, P.; Vattulainen, I. Influence of DPH on the structure and dynamics of a DPPC bilayer. Biophys. J. 2005, 88, 3398–3410. [Google Scholar] [CrossRef]
- Crowley, L.C.; Scott, A.P.; Marfell, B.J.; Boughaba, J.A.; Chojnowski, G.; Waterhouse, N.J. Measuring Cell Death by Propidium Iodide Uptake and Flow Cytometry. Cold Spring Harb. Protoc. 2016, 2016, 87163. [Google Scholar] [CrossRef] [PubMed]
- Liu, W.; Li, L.P.; Zhang, J.D.; Li, Q.; Shen, H.; Chen, S.M.; He, L.J.; Yan, L.; Xu, G.T.; An, M.M.; et al. Synergistic antifungal effect of glabridin and fluconazole. PLoS ONE 2014, 9, e103442. [Google Scholar] [CrossRef] [PubMed]
- Cui, J.; Ren, B.; Tong, Y.; Dai, H.; Zhang, L. Synergistic combinations of antifungals and anti-virulence agents to fight against Candida albicans. Virulence 2015, 6, 362–371. [Google Scholar] [CrossRef] [PubMed]
- Zhang, J.; Wu, X.; Zhong, B.; Liao, Q.; Wang, X.; Xie, Y.; He, X. Review on the Diverse Biological Effects of Glabridin. Drug Des. Devel. Ther. 2023, 17, 15–37. [Google Scholar] [CrossRef]
- Wayne, P.A.; Clinical and Laboratory Standards Institute (CLSI). Reference Method for Broth Dilution Antifungal Susceptibility Testing of Yeasts, 3rd ed.; Approved Standard, CLSI document M27-A3; Clinical and Laboratory Standards Institute (CLSI): Berwyn, PA, USA, 2008; Volume 28. [Google Scholar]
- Khabnadideh, S.; Rezaei, Z.; Pakshir, K.; Zomorodian, K.; Ghafari, N. Synthesis and antifungal activity of benzimidazole, benzotriazole and aminothiazole derivatives. Res. Pharm. Sci. 2012, 7, 65–72. [Google Scholar] [PubMed]
- Leong, C.; Buttafuoco, A.; Glatz, M.; Bosshard, P.P. Antifungal Susceptibility Testing of Malassezia spp. with an Optimized Colorimetric Broth Microdilution Method. J. Clin. Microbiol. 2017, 55, 1883–1893. [Google Scholar] [CrossRef]
- Cao, Y.Y.; Cao, Y.B.; Xu, Z.; Ying, K.; Li, Y.; Xie, Y.; Zhu, Z.Y.; Chen, W.S.; Jiang, Y.Y. cDNA microarray analysis of differential gene expression in Candida albicans biofilm exposed to farnesol. Antimicrob. Agents Chemother. 2005, 49, 584–589. [Google Scholar] [CrossRef]
- Lee, H.S.; Kim, Y. Paeonia lactiflora inhibits cell wall synthesis and triggers membrane depolarization in Candida albicans. J. Microbiol. Biotechnol. 2017, 27, 395–404. [Google Scholar] [CrossRef]
- Liu, Y.; Lu, J.; Sun, J.; Zhu, X.; Zhou, L.; Lu, Z.; Lu, Y. C16-fengycin A affect the growth of Candida albicans by destroying its cell wall and accumulating reactive oxygen species. Appl. Microbiol. Biotechnol. 2019, 103, 8963–8975. [Google Scholar] [CrossRef]
- Lee, H.S.; Kim, Y. Aucklandia lappa causes cell wall damage in Candida albicans by reducing chitin and (1,3)-β-D-glucan. J. Microbiol. Biotechnol. 2020, 30, 967–973. [Google Scholar] [CrossRef]
- Quan, H.; Cao, Y.Y.; Xu, Z.; Zhao, J.X.; Gao, P.H.; Qin, X.F.; Jiang, Y.Y. Potent in vitro synergism of fluconazole and berberine chloride against clinical isolates of Candida albicans resistant to fluconazole. Antimicrob. Agents. Chemother. 2006, 50, 1096–1099. [Google Scholar] [CrossRef] [PubMed]

| Candida Species | MIC50 (µg/mL) | MIC90 (µg/mL) |
|---|---|---|
| C. albicans | 250 | 500 |
| C. glabrata | 500 | 1000 |
| C. parapsilosis | 250 | 500 |
| C. krusei | 125 | 250 |
| C. tropicalis | 250 | 500 |
| C. auris | 250 | 500 |
Disclaimer/Publisher’s Note: The statements, opinions and data contained in all publications are solely those of the individual author(s) and contributor(s) and not of MDPI and/or the editor(s). MDPI and/or the editor(s) disclaim responsibility for any injury to people or property resulting from any ideas, methods, instructions or products referred to in the content. |
© 2024 by the authors. Licensee MDPI, Basel, Switzerland. This article is an open access article distributed under the terms and conditions of the Creative Commons Attribution (CC BY) license (https://creativecommons.org/licenses/by/4.0/).
Share and Cite
Janeczko, M.; Kochanowicz, E. Biochanin A Inhibits the Growth and Biofilm of Candida Species. Pharmaceuticals 2024, 17, 89. https://doi.org/10.3390/ph17010089
Janeczko M, Kochanowicz E. Biochanin A Inhibits the Growth and Biofilm of Candida Species. Pharmaceuticals. 2024; 17(1):89. https://doi.org/10.3390/ph17010089
Chicago/Turabian StyleJaneczko, Monika, and Elżbieta Kochanowicz. 2024. "Biochanin A Inhibits the Growth and Biofilm of Candida Species" Pharmaceuticals 17, no. 1: 89. https://doi.org/10.3390/ph17010089
APA StyleJaneczko, M., & Kochanowicz, E. (2024). Biochanin A Inhibits the Growth and Biofilm of Candida Species. Pharmaceuticals, 17(1), 89. https://doi.org/10.3390/ph17010089

